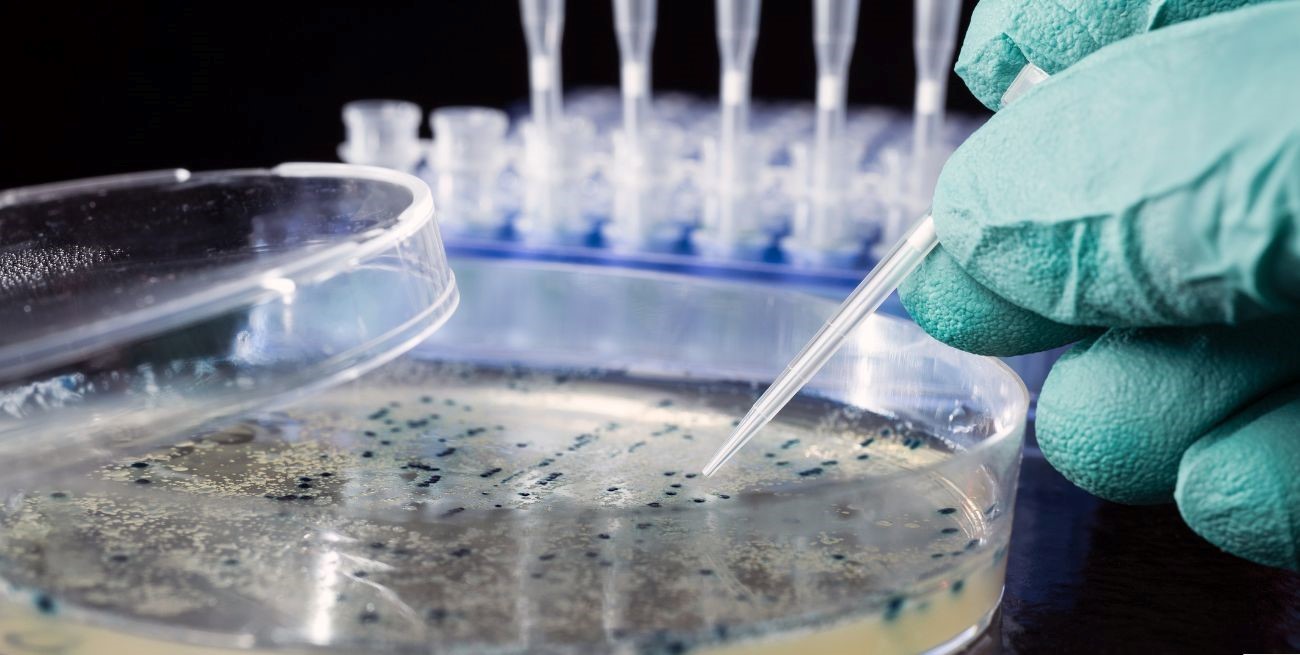
Un niño falleció por meningitis bacteriana en Chajarí

Un niño de la localidad de Chajarí perdió la vida a causa de un grave cuadro de meningitis bacteriana. El hospital Santa Rosa, donde estaba internado, emitió un comunicado este lunes por la mañana, en el que confirmaron el diagnóstico.
SALUD
Un niño falleció por meningitis bacteriana en Chajarí
Según informaron, desde el hospital se controlaron los carnets de vacunación a los compañeritos de curso del niño fallecido.
El comunicado
“Con el objetivo de llevar tranquilidad a la comunidad en general, ante el caso confirmado de Meningitis Bacteriana en paciente pediátrico, el Hospital Santa Rosa de Chajarí informa que se trata de un caso confirmado de Meningitis Bacteriana, que no requiere profilaxis. Es decir, no requiere aislamiento y ni medicación a los contactos.
Desde el Nodo de Epidemiología se realizaron las acciones que el protocolo establece para este tipo de diagnóstico. Se concurrió al Establecimiento Educativo para dialogar con las autoridades, se controlaron los carnets de vacunación a todos estudiantes del curso que concurría y se citaron a aquellos que no tienen esquema de vacunación completo.
Asimismo, desde el Hospital Santa Rosa de Chajarí se recordó la importancia de tener los esquemas de vacunación al día.
¿Qué es la meningitis?
La meningitis es una inflamación de las membranas que rodean el cerebro y la médula espinal, conocidas como meninges. Puede ser causada por infecciones virales, bacterianas o fúngicas. La meningitis bacteriana es especialmente grave y puede ser mortal si no se trata rápidamente. Los síntomas incluyen fiebre alta, dolor de cabeza intenso, rigidez en el cuello, náuseas, vómitos, sensibilidad a la luz y alteración del estado mental.
La vacunación es una de las formas más efectivas de prevenir la meningitis bacteriana. Mantener al día los esquemas de vacunación recomendados puede ayudar a proteger a los individuos y a la comunidad en general de esta enfermedad potencialmente mortal.


































